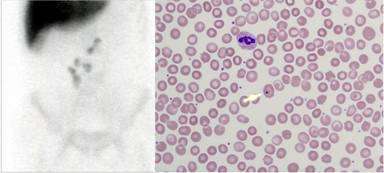

CASE REPORT
JOP. J Pancreas (Online) 2015 May 20; 16(3):299-302.
Spleen Autotransplantation Following Laparoscopic Distal Pancreatosplenectomy and Cholecystectomy
Sung Hwan Lee1,2, Dong Hyun Kim3, Ho Kyoung Hwang1,2, Chang Moo Kang1,2, Woo Jung Lee1,2
1Department of Hepatobiliary and Pancreatic Surgery, Yonsei University College of Medicine. Seoul, South Korea. 2Pancreaticobiliary Cancer Clinic, Yonsei Cancer Center, Severance Hospital. Seoul, South Korea. 3Department of Surgery, Yonsei University Wonju College of Medicine. Wonju, South Korea
ABSTRACT
Context The lifelong risk of post-splenectomy overwhelming sepsis is major complication after splenectomy. Laparoscopic distal pancreatectomy is an accepted as safe, and adequate procedure for pancreatic pathologies requiring resection of the distal part of the pancreas. However, attempts to preserve the spleen are not always successful and sometimes require unnecessary splenectomy. Spleen autotransplantation can be regarded as inducing iatrogenic splenosis in the abdominal cavity. Case report In this report, we present a case of spleen autotransplantation (about 30 g of splenic tissue) following laparoscopic distal pancreatectomy and inadvertent splenectomy for benign intraductal papillary tumor of the pancreas. Conclusion This procedure may be the last option spleen preservation considered in the era of laparoscopic distal pancreatectomy.
INTRODUCTION
The role of the spleen has been emphasized due to its significant contribution for immunologic function. The lifelong risk of postsplenectomy overwhelming sepsis is major complication after splenectomy [1], therefore, spleen preservation should be considered in patients with benign and borderline malignant diseases requiring splenectomy who can expect long-term survival [2]. Laparoscopic distal pancreatectomy is safe, accepted, and adequate procedure for pancreatic pathologies requiring resection of the distal part of the pancreas. Traditionally, distal pancreatectomies were frequently combined with splenectomy due to anatomical intimacy and surgeons’ convenience. With advances in laparoscopic instruments and experiences, however, spleen-preserving procedure has been recognized safe and feasible for benign and borderline malignant diseases requiring distal pancreatectomy. Currently, many laparoscopic surgeons make great efforts to preserve the spleen by either conserving the splenic vessels or removing segments of splenic vessels together with the distal pancreas, maintaining spleen perfusion with short gastric and left gastroepiploic vessels (Warshaw’s procedure) [3]. However, attempts to preserve the spleen are not always successful and sometimes require unintentional splenectomy.
In this report, we present a case of spleen autotransplantation following laparoscopic distal pancreatectomy and inadvertent splenectomy for intraductal papillary tumor of the pancreas. This procedure may be the last chance for the preservation of spleen in the era of laparoscopic distal pancreatectomy.
CASE REPORT
A seventy-two-year-old female patient visited our Department of Surgery due to incidental discovery of a cystic lesion in the distal pancreas and a gallbladder polyp during routine medical check-up. She did not complain any specific symptom and have significant medical history. The image study showed a cystic mass of approximately 2 cm in size in the tail of the pancreas and a gallbladder polyp of about 1 cm (Figure 1). Routine chemistry and tumor marker levels (CA 19-9, CEA) were all within normal limits. The patient was scheduled for spleen-preserving laparoscopic distal pancreatectomy with concomitant laparoscopic cholecystectomy for an intraductal papillary mucinous neoplasm of the pancreas and gallbladder polyp.

|
Figure 1. Preoperative image study. Abdominal CT scan showed a cystic mass in the tail of the pancreas and US revealed a gallbladder polyp of about 1 cm in size. |
Laparoscopic Resection
The patient was placed at the operative bed in the supine position. The surgeon and camera assistant stood on the right side of the patient while another assistant surgeon and scrub nurse stood on the opposite side. Total of 5 trocars (two 12 mm and three 5 mm) were used for the procedure. Spleen-preserving laparoscopic distal pancreatectomy with the preservation of the splenic artery and vein was attempted initially. A division of the gastrocolic ligament without a sacrifice of the left gastroepiploic artery was performed. The lienocolic and gastrolienal ligaments were not divided in this case. The whole pancreas could be inspected and the tumor was well identified. The distal pancreas containing the pancreatic cystic mass was mobilized by dissection of the retropancreatic avascular plane along the inferior margin of the pancreas. After a separation of the splenic vein from the pancreas, the splenic artery was carefully dissected. Following the creation of sufficient posterior window between the pancreas and splenic vessels, the body of the pancreas was transected using an Endo-GIA 60-3.5. Next, careful dissection between the pancreas and splenic vessels was continued by retracting the distal pancreas down. The distal pancreas containing the pancreatic cyst seemed to be severely adhered to the splenic vessels due to possible subclinical chronic pancreatitis. Tributary vessels around the distal pancreas were damaged during a dissection and resulted in severe intraoperative bleeding. We decided to convert the operation for the spleen preservation to Warshaw’s procedure. After the division of the splenic vessels, the dissection was continued to the tail of the pancreas. However, another incidence of inadvertent vascular damage of the left gastroepiploic artery led to significant splenic infarction. Combined splenectomy was thought to be unavoidable. After the completion of laparoscopic distal pancreatosplenectomy, the surgeon and camera assistant moved to the left side of the patient to perform concomitant laparoscopic cholecystectomy. An additional 5-mm trocar for retraction of the gallbladder was placed at the right flank area in the midaxillary line. Laparoscopic cholecystectomy was performed as the usual manner. The resected specimens from the pancreas, spleen, and gallbladder were placed into an impermeable plastic bag. The umbilical trocar site was vertically extended enough to enable extraction of the specimens.
Surgery-Spleen Autotransplantation
The spleen was sliced into several fragments measuring about 2x2x2 cm in size. Total six fragments of the spleen tissues weighing 30 g were prepared. The great omentum was withdrawn through the mini-laparotomy site. The fragments of spleen tissue were interruptedly sutured in the omentum with 3-0 absorbable synthetic suture materials (Figure 2). A silastic drain was placed around the surgical field of the distal pancreatosplenectomy through the left abdomen trocar site. An extended wound of about 4 cm was closed. The total operation time was about 5 hours, and the estimated blood loss during operation was 700 mL without transfusion.

|
Figure 2. Operative views. The spleen fragments were sutured onto the great omentum withdrawn through the mini-laparotomy site. Laparoscopic view after completion of spleen autotransplantation. |
Postoperative Course
The patient recovered without complications after operation. She returned to an oral diet on the 1st postoperative day. The drain was removed, and she was discharged on the 8th postoperative day. Pathologic examination for resected specimens revealed a benign intraductal papillary mucinous neoplasm of the pancreas and a gallbladder adenoma. A follow-up study after six months from operation showed significant uptake in spleen scan (Figure 3). There was relatively mild change in peripheral blood smear compared to total splenectomy patients (a few pitted cell and Howell-Jolly bodies, Figure 3). The follow-up immunoglobulin profile also indirectly suggested restoration of splenic function (Table 1), suggesting conserved spleen function. No vaccination was given.
|
Figure 3. Follow-up study. Spleen scan showed hot uptakes in the middle of the abdomen, suggesting splenosis. Peripheral blood smear revealed minimal change in blood morphology. |
Table 1. Immunologic and hematologic parameters following splenectomy.
|
POD # |
1 day |
1 month |
6 months |
|
Quantitation |
|
|
|
|
IgM (40-230 mg/dL) |
58.1 |
83.5 |
83.7 |
|
IgG (700-1600 mg/dL) |
701 |
981 |
1090 |
|
IgA (70-400 mg/dL) |
130 |
246 |
218 |
|
Kappa light chain (170-370 mg/dL) |
159 |
273 |
237 |
|
Lambda light chain (90-210 mg/dL) |
80.4 |
148 |
114 |
|
Platelet count (x103/µL) |
188 |
375 |
296 |
DISCUSSION
The splenosis is defined as spontaneous heterotrophic implantation of viable splenic tissue that occasionally occurs after trauma and iatrogenic rupture of the spleen [4]. Therefore, spleen autotransplantation can be regarded as inducing iatrogenic splenosis in the abdominal cavity. Several experimental and clinical studies have shown the potentials for residual splenic function after splenosis [5-7]. There are some clinical reports of spleen autotransplantation; however, only few reports have been introduced in minimally invasive meaning [8].
With recent developments in laparoscopic skills and experiences, laparoscopic surgery has evolved and become competitive to conventional open surgery [9]. Most laparoscopic surgeons surely try to preserve the spleen when performing laparoscopic distal pancreatectomy in benign and borderline malignant tumors of the pancreas [10]. In particular, the value of the spleen has been emphasized in case of laparoscopic distal pancreatectomy because post-splenectomy overwhelming sepsis is a critical complication after splenectomy when considering that patients are expected to have long-term survival after successful laparoscopic distal pancreatectomy [11]. However, spleen-preserving laparoscopic distal pancreatectomy is not always performed because it is difficult and time-consuming procedure. Surgeons need to be equipped with the adequate skills and experience. Recent reports show that the success rate of the spleen preservation in intended spleen-preserving laparoscopic distal pancreatectomy ranges from 40.8 to 81% [12-15]. Therefore, spleen autotransplantation following the laparoscopic distal pancreatectomy with unintended splenectomy can be another salvage strategy for restoring spleen function in benign and borderline malignant tumors of the pancreas requiring inevitable splenectomy as shown in this case.
Many experimental studies have demonstrated that the great omentum is the best place to implant a spleen tissue because of the abundant blood supply and physiologic venous drainage to the portal system, which is natural drainage route of the spleen for splenic function and metabolism [16]. In this case, we pulled out the great omentum through the mini-laparotomy site and sutured spleen fragments onto the omentum without difficulty in order to shorten operation time. A total laparoscopic approach is also feasible and the decision for operative techniques depends on the surgeons’ preference and patients’ general condition. We used about 30 g of spleen tissues for spleen autotransplantation. According to several studies, about 30-50 g of spleen tissue is thought to be adequate to maintain spleen function [17-19]. Too much spleen tissue can potentially develop the intra-abdominal abscess or postoperative adhesion. In the present case, the 6-months follow-up study would have demonstrated the evidence of residual splenic function. Not to mention of significant finding in the spleen scan, we could observe a gradual restoration of the lambda and kappa chains from the 1st postoperative day to 6 months after surgery. In addition, peripheral blood smear showed relatively minimal changes in peripheral blood morphology, indirectly suggesting potential functions for autotransplanted spleen, but the actual function of autotransplanted spleen is still under debate [20, 21]. There are also several studies showing no restored immunologic spleen function of autotransplanted spleen [22, 23]. Large-scale clinical studies to show real functions of implanted spleen in terms of immunologic and hematologic functions are necessary to reveal the effectiveness of spleen transplantation in the clinical setting.
In summary, we present a case of spleen autotransplantation following laparoscopic distal pancreatectomy with unnecessary splenectomy in a benign and borderline malignant tumor of the pancreas. Follow-up studies suggest potentially restored splenic functions of iatrogenically implanted spleen. “If the goal is to save the spleen, having options allows the surgeons to match the tactics to the terrain” [24]. Spleen autotransplantation may be the last option for the spleen preservation in the laparoscopic distal pancreatectomy.
Received February 20th, 2015 – Accepted March 28th, 2015
Keywords Pancreatectomy; Spleen; Transplantation, Autologous
Conflicting Interest The authors had no conflicts of interest
Correspondence Chang
Moo Kang
Department of HBP Surgery
Yonsei University College of Medicine
50 Yonsei-ro, Shinchon-dong, Seodaemun-gu
Seoul
Korea
Phone: +82-2.2228.2135
Fax: +82-2.313.8289
E-mail: cmkang@yuhs.ac
References
1. Schwartz PE, Sterioff S, Mucha P, Melton LJ, Offord KP. Postsplenectomy sepsis and mortality in adults. JAMA 1982; 248:2279-83. [PMID: 7131680]
2. Shoup M, Brennan MF, McWhite K, Leung DH, Klimstra D, Conlon KC. The value of splenic preservation with distal pancreatectomy Arch Surg 2002; 137:164-8. [PMID: 11822953]
3. Rodriguez JR, Madana MG, Healy BC, Thayer SP, Warshaw AL, Frenandez-del Castillo C. Distal pancreatectomy with splenic preservation revisited. Surgery 2007; 141:619-25. [PMID: 17462461]
4. Fremont RD, Rice TW. Splenosis: A review. South Med J 2007; 100:589-93. [PMID: 17591312]
5. Perason HA, Johnston D, Smith KA, et al. The born-again spleen: return of splenic function after splenectomy for trauma. N Engl J Med 1978; 298:1389-92. [PMID: 652006]
6. Zoli G, Corazza GR, D'Amato G, Bartoli R, Baldoni F, Gasbarrini G. Splenic autotransplantation after splenectomy: tuftsin activity correlates with residual splenic function. Br J Surg 1994; 81:716-8. [PMID: 8044558]
7. Lansdale N, Marven S, Welch J, Vora A, Sprigg A. Intra-abdominal splenosis following laparoscopic splenectomy causing recurrence in a child with chronic immune thrombocytopenic purpura. J Laparoendosc Adv Surg Tech A 2007; 17:387-90. [PMID: 17570795]
8. Petroianu A, Cabezas-Andrade MA, Neto RB. Laparoscopic splenic autotransplantation. Surg Laparosc Endosc Percutan Tech 2006; 16:259-62. [PMID: 16921309]
9. Lee SH, Kang CM, Hwang HK, Choi SH, Lee WJ, Chi HS. Minimally invasive RAMPS in well-selected left-sided pancreatic cancer within Yonsei criteria: long-term (>median 3 years) oncologic outcomes. Surg Endosc 2014; 28:2848-55. [PMID: 24853839]
10. Choi SH, Seo MA, Hwang HK, Kang CM, Lee WJ. Is it worthwhile to preserve adult spleen in laparoscopic distal pancreatectomy? Perioperative and patient-reported outcome analysis. Surg Endosc 2012; 26:3149-56. [PMID: 22580876]
11. Xu JL, Tang CW, Feng WM, Bao Y. Hematological benefits after spleen-preserving distal pancreatectomy: perioperative and long-term outcome analysis. Hepatogastroenterology 2013; 60:2103-6. [PMID: 24088313]
12. Kim SC, Park KT, Hwang JW, et al. Comparative analysis of clinical outcomes for laparoscopic distal pancreatic resection and open distal pancreatic resection at single institution. Surg Endo 2008; 22:2261-8. [PMID: 18528619]
13. Melotti G, Buturini G, Piccoli M, Casetti L, et al. Laparoscopic distal panceatectomy. Result on a consecutive series of 58 patients. Ann Surg 2007; 246:77-82. [PMID: 17592294]
14. The SH, Tseng D, Shppard BC. Laparoscopic and open distal pancreatic resection for benign pancreatic disease. J Gastroint Surg 2007; 11:1120-25. [PMID: 17623260]
15. Mabrut JY, Fernandez-Cruz L, Azagra JS, BassiC,et al. Laparoscopic pancreatic resection: results of a multicenter European study of 127 patients. Surgery 2005; 137:597-605. [PMID: 15962401]
16. Leemans R, Manson W, Snijder JAM, et al. Immune response capacity after human splenic autotransplanation. Ann Surg 1999; 229:279-85. [PMC ID: 1191642]
17. Holdsworth RJ, Regeneration of the spleen and splenic autotransplanatation. Br J Surg 1991; 78:270-8.
18. Corazza GR, Tarozzi C, Vaira D, Frisoni M, Gasbarrini G. Return of splenic function after splenectomy: how much tissue is needed? Br Med J 1984; 289:861-4 [PMID: 6434114]
19. Iinuma H, Okinaga K, Sato S, et al. Optimal site and amount of splenic tissue for autotransplantation. J Surg Res 1992; 53:109-116. [PMID: 1405598]
20. Leemans R, Harms G, Rijkers GT, Timens W. Spleen autotransplantation provides restoration of functional splenic lymphoid compartments and improves the humoral immune response to pneumococcal polysaccharide vaccine. Clin Exp Immunol 1999; 117:596-604. [PMID: 10469068]
21. Tzoracoleftherakis E, Alivizatos V, KalfarentzosF,Androulakis J. Complications of splenic tissue reimplantation. Ann R Coll Surg Engl 1991; 73:83-86. [PMID: 2018325]
22. Sasaki K. Splenic autotransplantation in nude mice. APMIS 1990; 98:507-13. [PMID: 2383395]
23. WillfuÈhr KU, Westermann J, Pabst R. Splenic autotransplantation provides protection against fatal sepsis in young but not in old rats. J Pediatr Surg 1992; 27:1207-12. [PMID: 1432531]
24. Warshaw A. Letter to the editor. Techniques of preserving the spleen in distal pancreatectomy J Am CollSurg 1999; 188:255-60.